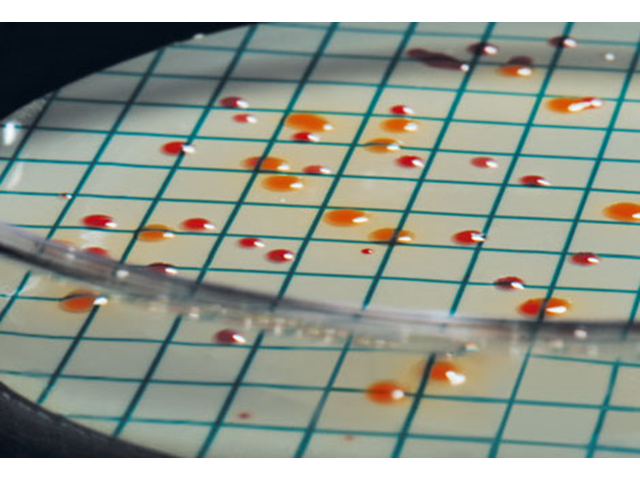

Hitta dina Produkter
Hitta dina Leverantörer
Hitta dina Branscher
Hitta dina Hållbara lösningar
Filterteknik
Vi har lösningar för att filtrera er vätska med ett brett sortiment från världens ledande tillverkare. Oavsett om ni söker påsfilter och påsfilterhus, strainer eller filterskikt så har vi lösningar för de flesta typer av behov. Behöver ni istället patronfilter och patronfilterhus, labfilter eller separatorer har vi produkter även för att hjälpa till med detta.
Vi har lösningar för såväl absolut som nominell filtrering och kan erbjuda flera olika typer av filtermedia och flera olika material på filterhus och strainers utifrån ert behov.
Våra filterlösningar hittar ni inom de flesta inriktningar såsom fordonsindustrin, kemiindustrin, elektronikindustrin, papper och massa samt övrig processindustri. Vi har även lösningar för livsmedel och dryck, läkemedel och hälsovård, kommunalt och industriellt vatten, så hör gärna av er till oss med er förfrågan så hjälper vi er vidare.